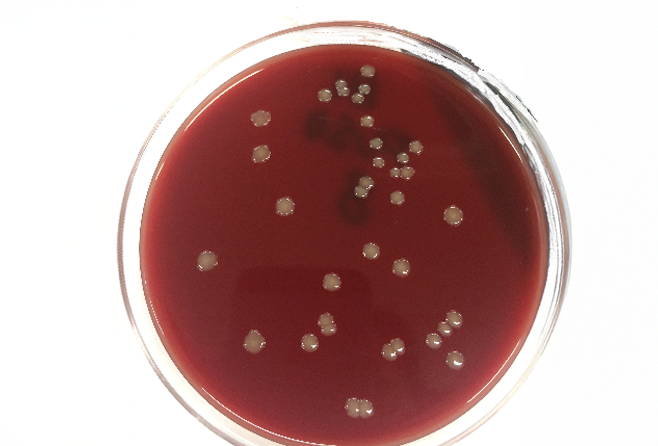

研究室
獣医微生物学研究室
学びのキーワード
- 病原細菌
- 薬剤耐性菌
- 腸内細菌
- 人獣共通感染症
担当教員


研究内容
微生物(主に細菌)を扱う研究室です。動物に病気を起こす細菌の培養と同定や定量、そして治療のための抗生物質の効果を調べています。


身につくこと
- 微生物の取り扱い
- 細菌培養方法
- 細菌の同定方法
- 分子生物学的手法
- プレゼンテーション能力
- 課題解決能力
SDGs












微生物(主に細菌)を扱う研究室です。動物に病気を起こす細菌の培養と同定や定量、そして治療のための抗生物質の効果を調べています。